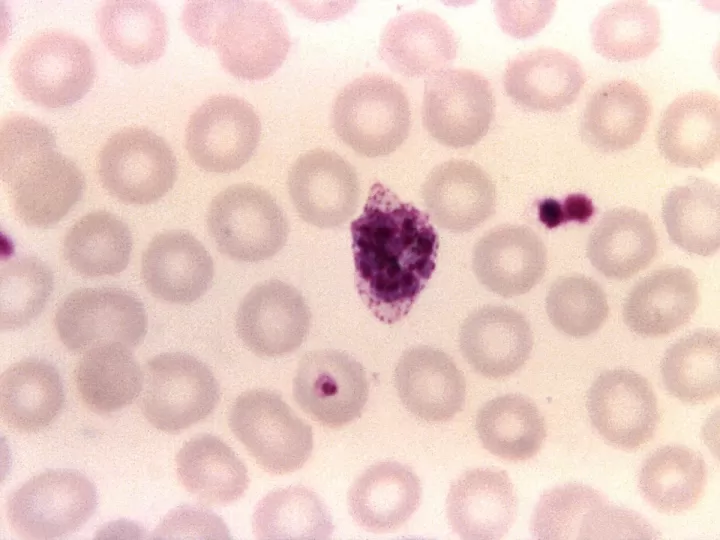
nucleos layens

Núcleos Layens de alta calidad tu mejor opción en cuidado de abejas
El núcleo Layens de 6 cuadros es una excelente opción económica y resistente, elaborada con tablero HDF laminado de alta densidad hidrófugo. Este material garantiza una protección contra la lluvia y la humedad, sin necesidad de ser repintado.
Hechos importantes sobre el diseño HDF del núcleo Layens
Fabricado en tablero HDF (High Density Fiber) hidrófugo de alta densidad laminado, este núcleo Layens de 6 cuadros es ideal para apicultores que buscan una opción robusta y económica para la gestión y venta de enjambres.
Su diseño permite ofrecer el núcleo como parte del enjambre sin elevar el costo final, brindando un valor agregado significativo al cliente.
Optimizado para la Venta de Enjambres: Este núcleo ha sido especialmente diseñado para ser incluido en la venta de enjambres, facilitando un aumento en el valor sin un costo adicional considerable.
Resistencia y Durabilidad: Gracias al uso de HDF hidrófugo, este núcleo garantiza una mayor durabilidad y resistencia a las condiciones meteorológicas adversas en comparación con los núcleos de cartón, lo que asegura su reutilización a lo largo de varias temporadas.
¿Qué es un núcleo Layens y qué lo hace tan especial?
El núcleo Layens es un tipo de colmena utilizada en la apicultura que debe su nombre a su creador, el francés Georges de Layens. Esta colmena se diferencia de otras por su diseño específico y sus características únicas, lo que la convierte en una de las favoritas entre los apicultores.
El núcleo Layens consta de dos cuerpos de cajas, cada una con 10 cuadros de tamaño grande y con una capacidad total de hasta 20 cuadros, lo que la hace una colmena de gran capacidad. Además, su diseño permite una buena ventilación y control de la temperatura, lo que favorece la salud de las abejas y la producción de miel.
Pero lo que hace realmente especial al núcleo Layens es su sistema de producción de miel. En lugar de utilizar cajones de almacenamiento, como en otros tipos de colmenas, este núcleo cuenta con una estructura vertical de cuadros, lo que facilita la extracción de la miel y reduce el estrés de las abejas durante el proceso.
Otra de las ventajas del núcleo Layens es su durabilidad. Su construcción en madera maciza y su sistema de ventilación evitan la acumulación de humedad y previene la aparición de hongos y enfermedades en la colmena, prolongando su vida útil y permitiendo un manejo más sencillo y eficiente.
Su capacidad, su sistema de producción de miel y su durabilidad la convierten en una elección cada vez más popular en la apicultura moderna.
Si eres un apicultor o estás interesado en incursionar en este mundo, no dudes en considerar el uso de un núcleo Layens para tus colmenas. ¡Seguramente no te arrepentirás!
Ventajas del núcleo Layens de 6 cuadros frente a otros modelos de colmena
El mundo de la apicultura está en constante evolución y cada vez son más los apicultores que buscan mejorar sus colmenas. En este sentido, el núcleo Layens de 6 cuadros se ha convertido en una excelente opción para aquellos que deseen tener un manejo más eficiente y productivo de sus colmenas. A continuación, te presentamos las principales ventajas de este modelo de colmena frente a otros modelos tradicionales.
Mayor capacidad de producción
Una de las principales ventajas que ofrece el núcleo Layens de 6 cuadros es su mayor capacidad de producción. Gracias a su tamaño y diseño, esta colmena permite tener una cantidad mayor de abejas dentro, lo que se traduce en una mayor producción de miel y otros productos derivados de la colmena.
Menor esfuerzo en su mantenimiento
Otra de las ventajas de este modelo de colmena es que su mantenimiento es mucho más sencillo y requiere de menos esfuerzo que otros modelos. Al tener solo 6 cuadros, se facilita la tarea de revisión y manipulación de la colonia, lo que se traduce en un menor estrés para las abejas y una mayor comodidad para los apicultores.
Fácil manipulación y transporte
El núcleo Layens de 6 cuadros es altamente versátil y fácil de manipular, lo que facilita su transporte de un lugar a otro. Además, su diseño permite una mejor adaptabilidad a diferentes condiciones climáticas y zonas geográficas, lo que lo hace ideal para su uso en distintos entornos.
Menor riesgo de enjambrazón
Uno de los mayores problemas a los que se enfrentan los apicultores es la enjambrazón de las abejas, es decir, la formación de una nueva colonia a partir de la división de la colmena original. Sin embargo, con el núcleo Layens de 6 cuadros, este riesgo es mucho menor debido a su tamaño y diseño que permiten un mejor control y manejo de la colonia.
Su capacidad de producción, facilidad de mantenimiento y transporte, y menor riesgo de enjambrazón lo convierten en una opción atractiva y viable para mejorar la productividad en el mundo de la apicultura.
Materiales de construcción del núcleo Layens y su resistencia contra la lluvia y la humedad
Los materiales utilizados en la construcción del núcleo Layens son fundamentales para garantizar la durabilidad y resistencia de este tipo de colmena. En especial, la lluvia y la humedad son factores que pueden afectar su funcionamiento y poner en riesgo la salud de las abejas. Es por ello, que es importante elegir adecuadamente los materiales a utilizar.
¿Qué materiales son ideales para la construcción del núcleo Layens?
El núcleo Layens está compuesto por diferentes elementos, entre ellos:
La madera es uno de los materiales más importantes en la construcción del núcleo Layens. Es resistente y duradera, además de ser un excelente aislante térmico y proteger a las abejas de las variaciones climáticas. Por esta razón, es recomendable utilizar madera tratada para evitar posibles podredumbres causadas por la lluvia y la humedad. Por otro lado, la tela metálica y el tejido de algodón también son importantes para la ventilación y protección del núcleo.
¿Cómo proteger el núcleo Layens contra la lluvia y la humedad?
Para garantizar la resistencia del núcleo Layens frente a la lluvia y la humedad, es importante tomar ciertas medidas de protección, como por ejemplo:
Es importante tomar estas medidas de precaución para garantizar la durabilidad y resistencia del núcleo Layens, permitiendo a las abejas desarrollarse de manera óptima y producir miel de alta calidad.
¿Cómo funciona el tablero HDF laminado de alta densidad hidrófugo en el núcleo Layens?
El tablero HDF laminado de alta densidad hidrófugo en el núcleo Layens es un material de construcción ampliamente utilizado en la industria de la construcción por sus excelentes propiedades y durabilidad.
El proceso de fabricación de este tipo de tableros comienza con la extracción y secado de la madera, la cual luego es cortada en finas láminas y sometidas a altas temperaturas y presión con la ayuda de resinas y adhesivos sintéticos. Esto produce una lámina de alta densidad, resistente y altamente comprimida.
Lo más importante es que el núcleo de este tablero está compuesto por fibras de madera prensadas en una dirección específica, lo que le otorga una mayor resistencia, estabilidad y durabilidad. Además, su capa superior laminada le proporciona una superficie impermeable, lo que lo convierte en un material altamente hidrófugo.
Otras de sus características importantes son su fácil manejo y su capacidad para soportar grandes cargas sin deformarse ni expandirse, lo que lo hace ideal para su uso en estructuras y mobiliario.
¿Por qué el núcleo Layens de 6 cuadros es una opción económica para los apicultores?
La apicultura se ha convertido en una actividad cada vez más popular entre los amantes de la naturaleza y la miel. Sin embargo, para aquellos que están iniciando en este apasionante mundo, puede resultar abrumador tener que invertir grandes sumas de dinero en equipos y colmenas.
Es por eso que el núcleo Layens de 6 cuadros se ha convertido en una opción cada vez más buscada por los apicultores. Este tipo de colmena ofrece numerosas ventajas que lo hacen una opción económica y eficiente.
¿Qué es el núcleo Layens de 6 cuadros?
El núcleo Layens de 6 cuadros es una colmena que se caracteriza por su tamaño reducido y su facilidad de manejo. Está compuesto por seis cuadros de dimensiones estándar, que permiten una buena producción de miel y un adecuado desarrollo de la colonia.
Además, su diseño permite una rápida expansión de la colmena, lo que facilita el crecimiento de la colonia y la producción de miel.
¿Por qué es una opción económica?
El núcleo Layens de 6 cuadros es una opción económica por varias razones:
Además, su diseño permite una sencilla expansión y un buen desarrollo de la colonia. Sin duda, un gran aliado para aquellos que están iniciando en la apicultura.







